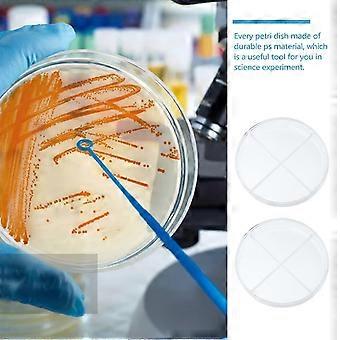
product image

10 τεμ γυαλί Petri πιάτα καπάκια δείγμα πιάτο πλαστικό αποστειρωμένο δοχείο Petri γυαλί Petri πιάτο χημεία
+ 7,49 € Αποστολή

10 τεμ γυαλί Petri πιάτα καπάκια δείγμα πιάτο πλαστικό αποστειρωμένο δοχείο Petri γυαλί Petri πιάτο χημεία
- Μάρκα: Unbranded
10 τεμ γυαλί Petri πιάτα καπάκια δείγμα πιάτο πλαστικό αποστειρωμένο δοχείο Petri γυαλί Petri πιάτο χημεία
- Μάρκα: Unbranded
Δεχόμαστε τους ακόλουθους τρόπους πληρωμής
Περιγραφή
10 τεμ γυαλί Petri πιάτα καπάκια δείγμα πιάτο πλαστικό αποστειρωμένο δοχείο Petri γυαλί Petri πιάτο χημεία
- Μάρκα: Unbranded
- Κατηγορία: Πιάτα Πέτρι
-
Méret: 9x9εκ.
-
Szín: Διαφανές χρώμα
- Fruugo ID: 383202706-825019873
- EAN: 7755063515239
Πληροφορίες για την ασφάλεια του προϊόντος
Δείτε τις πληροφορίες για την ασφάλεια του προϊόντος που περιγράφονται παρακάτω
Die folgenden Informationen werden vom unabhängigen Drittanbieter bereitgestellt, der dieses Produkt verkauft.
Ετικέτες ασφάλειας προϊόντων

Παράδοση & Επιστροφές
Αποστέλλεται σε 24 ώρες
-
STANDARD: 7,49 € - Παράδοση μεταξύ Πέμ 11 Δεκεμβρίου 2025–Δευ 29 Δεκεμβρίου 2025
Αποστέλλεται από Κίνα.
Κάνουμε ό,τι καλύτερο μπορούμε για να εξασφαλίσουμε ότι τα προϊόντα που παραγγέλνετε αποστέλλονται σε εσάς πλήρως και σύμφωνα με τις προδιαγραφές σας. Παρ' όλα αυτά, αν παραλάβετε μία ελλιπή παραγγελία ή προϊόντα διαφορετικά από αυτά που παραγγείλατε ή αν υπάρχει κάποιος άλλος λόγος που δεν είστε ικανοποιημένοι με την παραγγελία, μπορείτε να την επιστρέψετε ολόκληρη ή κάποια προϊόντα από αυτή και να λάβετε πλήρη επιστροφή χρημάτων για τα προϊόντα. Προβολή πλήρους πολιτικής επιστροφών
Details zur Produktkonformität
Bitte beachten Sie die unten aufgeführten Konformitätsinformationen zu diesem Produkt.
Die folgenden Informationen werden vom unabhängigen Drittanbieter bereitgestellt, der dieses Produkt verkauft.
Κατασκευαστής:
Οι παρακάτω πληροφορίες αφορούν τα στοιχεία επικοινωνίας του κατασκευαστή του σχετικού προϊόντος που πωλείται στο Fruugo.
- Haerbinshicunzoudianzishangwuyouxiangongsi
- Haerbinshicunzoudianzishangwuyouxiangongsi
- Apartment 603, Unit 4, Building B, Yiyuan Community, No. 35, Songbei Road, Harbin, Heilongjiang Province, China
- Heilongjiang Province
- China
- 150000
- djjty1321@163.com
- https://www.fruugo.co.uk/haerbinshicunzoudianzishangwuyouxiangongsi/m-20907
Υπεύθυνος στην ΕΕ:
Οι παρακάτω πληροφορίες αφορούν τα στοιχεία επικοινωνίας του επευθύνου στην Ε.Ε. Ο υπεύθυνος είναι ο καθορισμένος οικονομικός φορέας που εδρεύει στην Ε.Ε. και είναι υπεύθυνος για τις υποχρεώσεις συμμόρφωσης που αφορούν το σχετικό προϊόν που πωλείται στην Ευρωπαϊκή Ένωση.
- APEX CE SPECIALISTS
- APEX CE SPECIALISTS
- 64 Rue Waldeck-Rousseau 69006,Lyon
- RHONE/LYON
- France
- 69006
- Julien@specialisis.com
- 33 745436814
- https://www.fruugo.co.uk/haerbinshicunzoudianzishangwuyouxiangongsi/m-20907